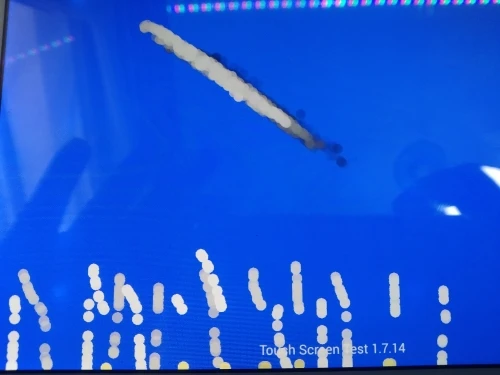

Envío Gratis para Chuwi Vi8 Onda V820W FPC-FC80J107-03 Tablet pantalla táctil Digitalizador de Panel táctil vidrio de sustitución con Sensor
6.20
$
49
pedidos
/
10
opiniones
Historial de precios
- para 3 mes
- para medio año
- Requiere la extensión Alitools
Se requiere la extensión Alitools para realizar un seguimiento de un artículo y recibir notificaciones cuando bajan los precios.
Notificación de bajada de precios
5.89 $ (-5%)
5.89 $ (-5%)
5.58 $ (-10%)
5.27 $ (-15%)
4.96 $ (-20%)
Nuestro bot de telegramas le notificará cuando el precio baje al deseable
Este artículo es de otros vendedores
Productos similares
Opiniones de los usuarios
M***r
27 de septiembre de 2020
excelente atención y el envío llegó antes de lo esperado, y en buen estado.
j***a
7 de septiembre de 2020
producto es el que necesitaba. tactil justo para mi tablet v820 que tuve mucho tiempo sin utilizar por que estaba dañada. el vendedor envio rapido a chile. pero por la pandemia en mi pais la internación ha demorado un poco. pero muy excelente servicio de la post venta. volvere a comprar con este vendedor. gracias por todo